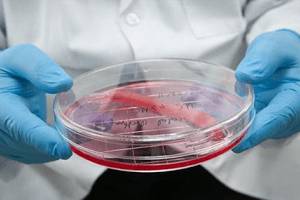
Мазок

Увеличенная простата часто обнаруживается при медицинском осмотре у мужчин. Изменение размеров происходит благодаря развитию воспалительного процесса. Процесс влечет появление простатита. Простатит носит различный характер и вызывает появление разнообразных симптомов. Установить причины простатита можно только при медицинском обследовании. Самостоятельно поставить диагноз не удастся.
Характеристики заболевания
Простатит развивается в предстательной железе. Орган состоит из нескольких долек. Внешне он напоминает грецкий орех. Нормальным размером считается диаметр до 5 см. Если размеры больше этой цифры, то возможно появление простатита. Симптоматика заболевания зависит от расположения простаты. Она располагается на верхней части мочевыводящих путей. Сверху на простату ложится мочевой пузырь.
В предстательной железе вырабатывается секрет спермы. Также в ней продуцируется мужской гормон, отвечающий за формирование половых признаков и половую активность. Выработка данных веществ начинается у мальчиков в подростковый период. Предстательная железа до этого времени растет постепенно. При начале половой активности простата резко увеличивается. При полном развитии функций орган сохраняет свои размеры.
Под воздействием различных причин происходит появление воспалительного процесса. Орган меняет свои размеры. При осмотре диагностируется увеличенная предстательная железа. Патологический процесс может иметь два механизма развития:
- Инфекционный;
- Другие пути появления.
Инфекционный простатит чаще встречается у современных мужчин. Он носит бактериальный характер. При попадании патогенных микроорганизмов в мочеиспускательные пути происходит увеличение колоний микробов. Бактерии питаются полезной микрофлорой мочевыводящей системы. Происходит гибель полезных микроорганизмов. Патогенные бактерии переходят в верхнюю часть путей и перемещаются в предстательную железу. В органе микробы развиваются и активно размножаются. Микроорганизмы поедают клетки тканей простаты. На месте их локализации скапливаются погибшие ткани и продукты жизнедеятельности. Эти вещества вызывают воспаление внутренней стенки простаты.
Сложности вызывает неинфекционная форма простатита. При этой форме заболевания сложно выявить причину воспаления. Чтобы правильно назначить лечение, больному необходимо пройти сложное и объемное обследование.
Также простатит подразделяется и по этиологии течения. Выделяется хронический вид воспаления предстательной железы и его острая форма. Обе формы имеют схожие симптомы. Отличием является время проявления патологических признаков заболевания.
Врачи отмечают, что увеличенная простата, или доброкачественная гиперплазия предстательной железы, может существенно повлиять на качество жизни мужчин. Основные последствия этого состояния включают затрудненное мочеиспускание, частые позывы к мочеиспусканию, особенно ночью, и ощущение неполного опорожнения мочевого пузыря. Эти симптомы могут привести к развитию психологического дискомфорта, снижению сексуальной функции и даже депрессии. Кроме того, хроническое задерживание мочи может вызвать инфекции мочевыводящих путей и привести к более серьезным осложнениям, таким как почечная недостаточность. Врачи подчеркивают важность ранней диагностики и своевременного лечения, чтобы минимизировать риски и улучшить общее состояние здоровья пациентов.

Причины бактериального простатита
Причиной бактериального простатита является бактерия. Часто при исследовании мазка выявляется стафилококк или стрептококк. Данный вид микроорганизмов не имеет сложных путей развития. Бактерия является анаэробной и не гибнет без наличия кислорода. Микроорганизм хорошо переносит перепад температур в организме. Гибель стафилококка наступает только при 70 градусах.
В редких случаях простата увеличивается при поражении другими видами бактерий, большинство из которых вызывает венерические инфекции. Устраняется данная форма патологии при помощи различных лекарственных препаратов.
Причины неинфекционного простатита
При этой патологии также диагностируется увеличенная предстательная железа. Простата меняет свои размеры благодаря таким патологическим факторам, как:
Изменение гормонального фона;
- Резкий перепад температур;
- Повреждение органа;
- Сопутствующие патологии в организме;
- Неправильный образ жизни;
- Профессиональные особенности мужчины.
Изменение гормонального фона влияет на количество тестостерона в простате. Вещество перестает влиять на продуцирование органом секрета семенной жидкости. Простата начинает увеличиваться. Происходит постепенное развитие неинфекционного простатита. Патология легко устраняется при помощи гормональных препаратов.
Также причиной появления заболевания считается и резкий перепад температур. Посещение сауны подразумевает остывание тела в бассейне после горячей парилки. Это вызывает резкое изменение температуры в организме. Предстательная железа является чувствительным органом. Частые изменения температуры влекут воспалительный процесс в простате.
Заболевание развивается и при повреждении тканей простаты. При сильном ударе или ушибе возникает сдавливание тканей предстательной железы. Деформация влечет частичную гибель клеток органа. Это сопровождается простатитом. Врачи рекомендуют при ушибе крестцового отдела посетить травматологию. Своевременное обращение позволит быстро устранить патологический процесс.
Влияет на болезнь неправильный образ жизни пациента. Многие мужчины злоупотребляют алкоголем и предпочитают жирные и жареные продукты. Данные привычки влекут патологические изменения в органах. Это связано с нарушением работы гормональной системы и липидного обмена. Гормоны перестают влиять на функцию простаты. Липидная система вызывает накопление излишек жировых отложений. Набор веса и гормональный сбой пагубно воздействуют на состояние предстательной железы. Похожие процессы возникают и при малоподвижном образе жизни. Если у пациента низкая физическая активность, происходит нарушение функций этих же систем.
Малая подвижность также зависит от профессии мужчины. При длительном нахождении на одном месте в организме замедляются обменные процессы. Происходит нарушение поставки кислорода. Клетки перестают активно размножаться. Наблюдается накопление погибших тканей.
Многие мужчины, сталкивающиеся с проблемой увеличенной простаты, отмечают, что это значительно влияет на качество их жизни. Частые позывы к мочеиспусканию, особенно ночью, становятся настоящим испытанием. Некоторые говорят о том, что это вызывает у них чувство дискомфорта и даже стресса, так как они постоянно беспокоятся о доступности туалета. Кроме того, многие отмечают, что проблемы с мочеиспусканием могут негативно сказаться на интимной жизни, вызывая неуверенность и снижение либидо. Важно отметить, что мужчины часто стесняются обсуждать эту тему, что приводит к изоляции и отсутствию поддержки. Однако открытое обсуждение и консультации с врачом могут помочь найти эффективные решения и улучшить общее состояние здоровья.

Симптоматика заболевания
Симптомы увеличенной простаты схожи при обеих формах поражения. У мужчины возникают определенные жалобы.
Основной жалобой является нарушение мочевыведения. Увеличенный орган оказывает давление на нижнюю часть мочевого пузыря.

Также данное явление усиливается в ночное время. Застойная жидкость покидает карман в лежачем положении. Пациент встает, и она перемещается обратно в карман. Процесс возникает постоянно при нахождении в лежачей позе. Это влечет прерывание сна человека. Появляется раздражительность, вялость, сонливость. Нарушается психоэмоциональный фон.
Тяжелая форма простатита влечет сильное увеличение простаты. Она полностью перекрывает мочеиспускательный канал. Мочевыведение прекращается или становится капельным. Жидкость выделяется непроизвольно. Возникает недержание или закупорка. Это явление требует незамедлительного врачебного вмешательства.
Простатит может сопровождаться и болезненными ощущениями в нижней части брюшины или при опорожнении кишечника. Боль также возникает и при выведении мочи. Снять болезненность помогают только спазмолитики.
Диагностика заболевания
При увеличенной простате необходимо пройти медицинское обследование. Для исследования используются различные методы. Аппаратный осмотр проводится при помощи ультразвукового исследования. На экране специалист отмечает увеличенные границы органа и выявляет пораженный участок тканей. В отдельных случаях проводится магнитно-резонансная томография. Этот вид обследования назначается с целью исключения онкологических заболеваний.
Необходимо также взять мазок из уретры пациента. Процедура болезненная, но необходимая. Мазок позволяет изучить содержание микрофлоры уретрального канала. При помещении в специальную емкость специалисты формируют благоприятную среду для развития микроорганизмов. Разросшаяся колония бактерий помогает установить природу простатита и причину увеличенной простаты.

Методы лечения
Увеличенная предстательная железа требует незамедлительного лечения. Для терапии используют различные методы. Основное терапевтическое воздействие оказывается такими способами, как:
- Лекарственная терапия;
- Мануальное воздействие;
- Магнитное тепло.
Лекарственная терапия проводится комбинацией медикаментов. Для устранения отека с простаты необходимо использовать антибиотические лекарственные препараты и противовоспалительные средства. Антибиотики подбираются в зависимости от чувствительности бактерий. Если же бактерий не обнаруживается, назначаются препараты широкого спектра действия. Они эффективны против большой группы болезнетворных микроорганизмов.
Противовоспалительные средства помогают значительно уменьшить отек. При снятии отечности с мочевыводящих путей отток жидкости из пузыря усиливается. Также назначаются лекарственные средства, которые усиливают выведение мочи. Данные вещества обладают сильным спазмолитическим действием. Происходит быстрое очищение пузыря от застойной жидкости.

Подобным же действием обладает и электростимуляция простаты. Тепло при этом выделяется с помощью электрического тока. Но этот вид лечения помогает быстро уменьшить объемы простаты. Под влиянием электрического тепла воспаленные ткани тают. Стенки простаты принимают нормальную форму.
Современные медики рекомендуют воспользоваться и услугами массажиста. Массаж предстательной железы усиливает кровообращение в малом тазу.
Кровь начинает доставлять больше кислорода к тканям. Клетки активно размножаются. Поврежденные участки быстрее восстанавливаются. Массаж рекомендуется совмещать и с иглоукалыванием. Иглы устанавливаются на области поясницы и усиливают положительное воздействие массажа. Оба вида мануального воздействия должен осуществлять квалифицированный специалист.
Во время лечения пациенту рекомендуется отказаться от различных вредных привычек. Особенно требуется уделить внимание своему питанию. В пище не должны присутствовать животные жиры. Способ приготовления исключает жарку продуктов. Можно увеличить также употребление продуктов, содержащих природные андрогены. Данные вещества замещают недостаток тестостерона и способствуют восстановлению гормонального фона. Необходимо полностью исключить прием спиртосодержащих напитков. Они оказывают губительное воздействие на работу предстательной железы и сперматогенез. Если же эти правила не соблюдаются, то и терапия не даст должного эффекта. Лечение в этом случае затянется на длительный срок.

Правильное лечение увеличенной простаты позволяет быстро устранить патологический процесс. Также своевременное лечение исключает развитие различных осложнений, одним из которых является бесплодие и импотенция.
Вопрос-ответ
Чем опасна увеличенная простата?
С возрастом увеличившаяся в размерах простата может сдавливать мочевыводящие пути, что приводит к проблемам с мочеиспусканием, а при отсутствии лечения — к нарушению работы почек.
Что чувствует мужчина после удаления простаты?
После полного или частичного удаления железы пациенты сталкиваются чаще всего с проблемами мочеиспускания, кровотечениями, мочеполовыми инфекциями, острой задержкой мочи и др. При проведении трансуретральной резекции омывающая жидкость, которая используется в процессе операции, может попасть в кровоток.
Можно ли уменьшить увеличенную простату?
Для уменьшения симптомов ВРН могут быть назначены лекарственные препараты. Некоторые препараты действуют путем расслабления мышц простаты и шейки мочевого пузыря, улучшая отток мочи. Другие приводят к уменьшению увеличенной простаты.
Можно ли вести половую жизнь при аденоме простаты?
Аденома и половая жизнь не совместимы. Бесспорно, заболевание влияет на естественные процессы эрекции и эякуляции (пациент испытывает трудности). Однако аденома не оказывает никакого отрицательного влияния на половое влечение, ощущения и психоэмоциональную составляющую во время половой близости.
Советы
СОВЕТ №1
Регулярно проходите медицинские обследования. Обращение к врачу для проверки состояния простаты поможет выявить проблемы на ранней стадии и предотвратить серьезные последствия.
СОВЕТ №2
Следите за своим питанием. Употребление продуктов, богатых антиоксидантами, таких как фрукты и овощи, может помочь поддерживать здоровье простаты и снизить риск ее увеличения.
СОВЕТ №3
Поддерживайте активный образ жизни. Регулярные физические упражнения способствуют улучшению кровообращения и могут помочь в снижении симптомов, связанных с увеличенной простатой.
СОВЕТ №4
Обратите внимание на симптомы. Если вы заметили изменения в мочеиспускании, такие как частые позывы или затруднения, не откладывайте визит к врачу для консультации и диагностики.

Изменение гормонального фона;